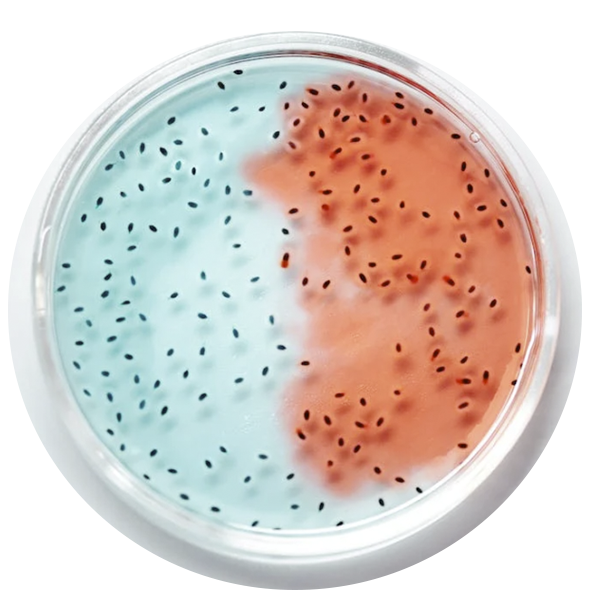

Laboratorio
Acreditaciones por:
Autorizaciones ante SADER- SENASICA
Laboratorio de Control de Calidad Interno con número de autorización C.C.072
Laboratorio de Constatación con número de autorización AUTOConst-042
Laboratorio de Ensayo Acreditado por ema.A.C.
National Forage Testing Association
Association of American Feed Control Officials
Cumberland Valley Analytical Services
ANFACA | Laboratorio de Servicios Gaq
ANFACA les da beneficios a sus socios
Manda al laboratorio tus muestras y nosotros te proporcionamos la información analítica para que diseñes el mejor alimento balanceado para tu ganado bovino, rumiantes, porcino, avícola y pequeñas especies.